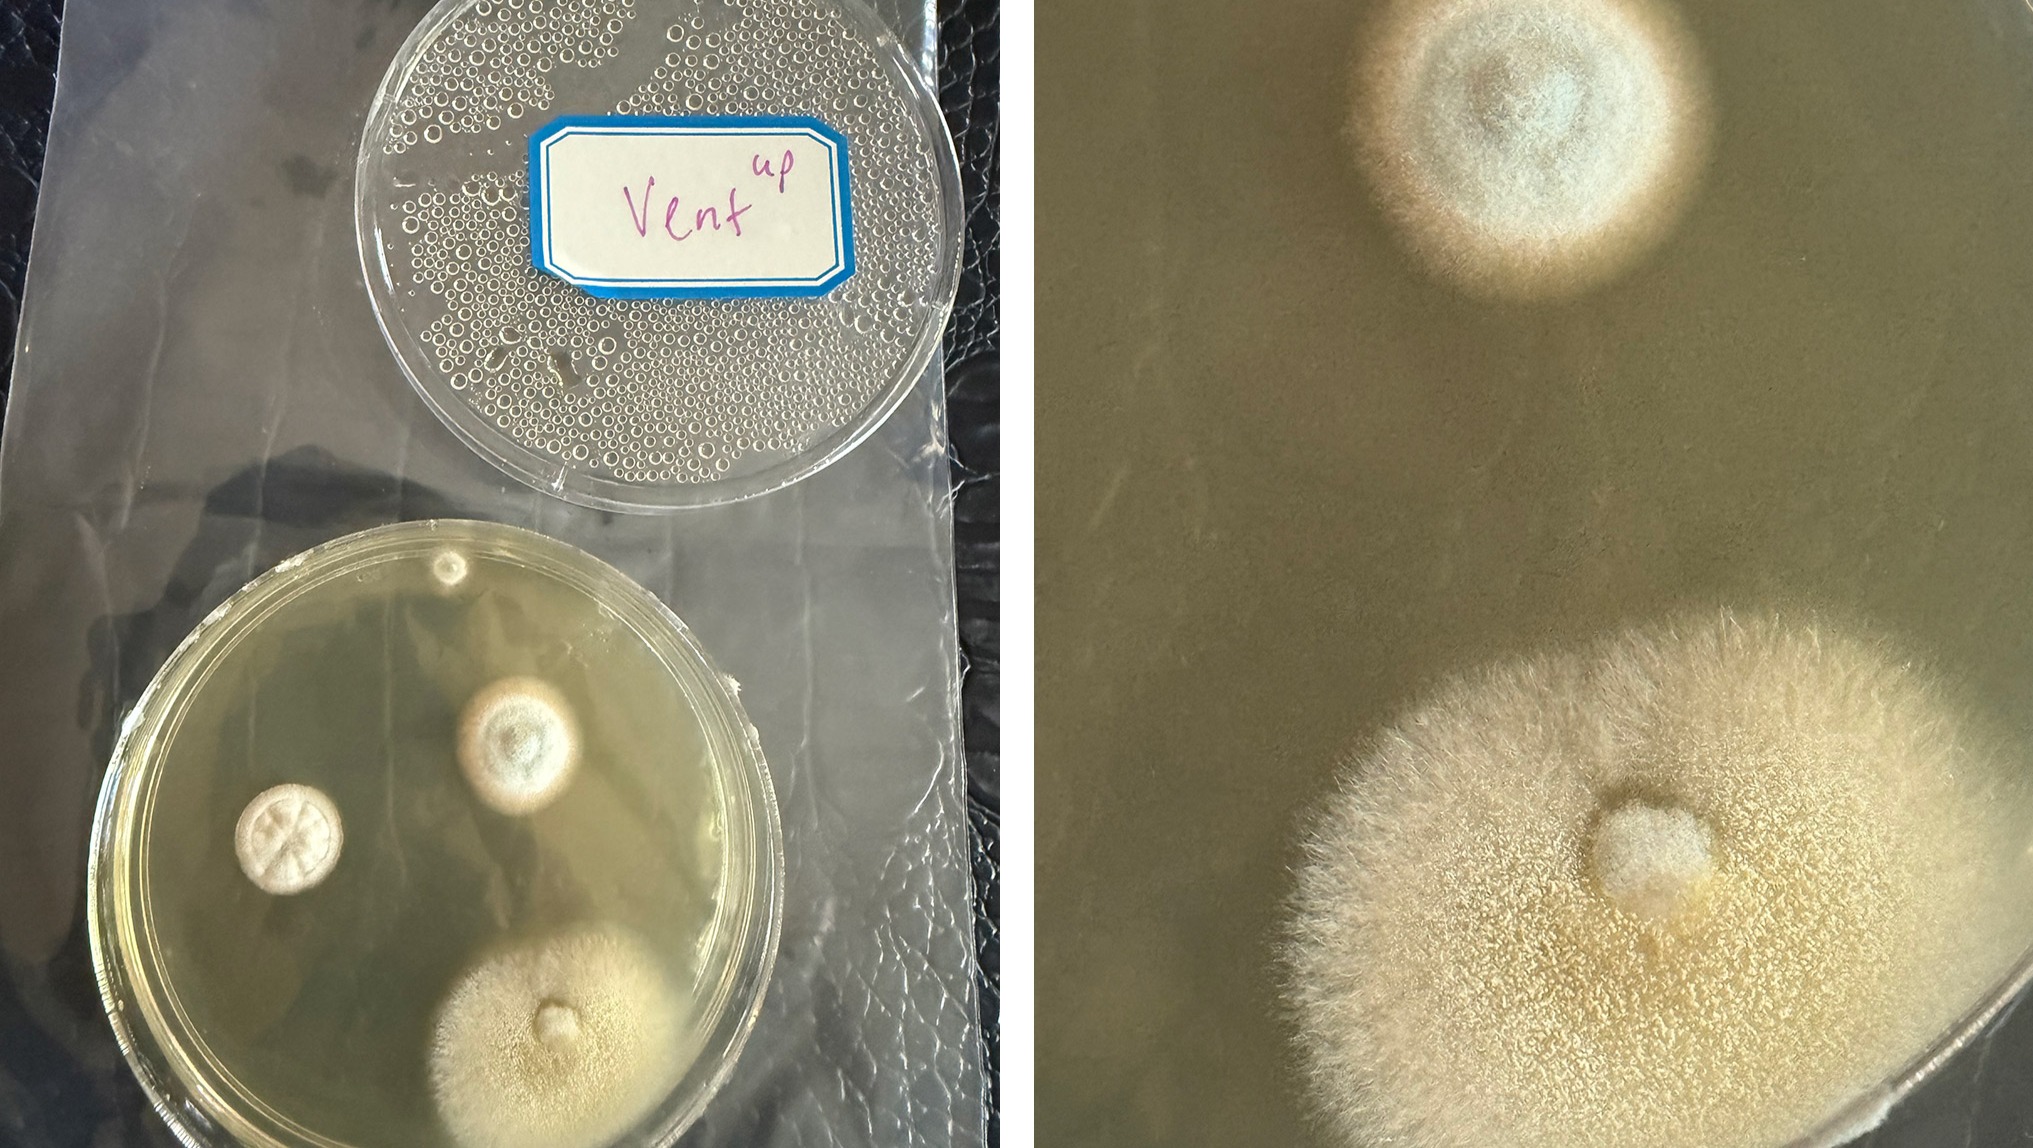

- R
Hi, I'm Alix, and I'm creating this GoFundMe in support of my very best friend, Sara. She’s an incredible person who’s facing a difficult time and deserves the chance to focus on her health and wellbeing. I believe in her strength, and I’m hopeful that—with a little help—brighter days are ahead. Thank you for being here, let’s support her in this journey together!
Over the past few years, she's been quietly fighting a battle she never expected—one that’s affected her body, mind, finances, and her ability to show up for her family and community the way she used to.
Sara lived in the same apartment for three and a half years with her three daughters, Zayla, Vada and Yuli. In March 2024, when they moved out, she discovered something horrifying: toxic black mold growing up the wall of the HVAC system—the very air we had been breathing every day. Sara had already been experiencing strange and debilitating symptoms: fatigue, brain fog, joint pain, circulation issues, eye disturbances, and neurological dysfunction. Later, Sara would learn she was suffering from black mold toxicity—her own home had slowly poisoned her body.
Sara Thought She Found the Answer—But It Wasn’t the Full Picture
During that time, Sara was also diagnosed with inattentive ADHD. For a while, she thought that explained everything. Sara started medication and made lifestyle adjustments. Her focus improved—but her physical symptoms never stopped. In fact, they intensified.
Since then, Sara has:
Seen eight different specialists
Had over 30 medical visits and more blood tests than she can count
Spent thousands of dollars on protocols, supplements, and healing regimens
Watched her body still decline, despite doing everything “right”
Sara's recent labs show:
Low protein levels
Low HDL (good cholesterol)
Elevated glucose, despite clean eating and consistent care
Unfortunately, she was denied help when she needed it most.
In early 2024, Sara was forced to take a medical leave from work—but was denied short-term disability because she couldn’t offer a “clear enough” diagnosis. With no income, Sara drained her savings and 401(k) just to survive. She ended up returning to work in October 2024, long before she was physically or mentally ready, simply because there was no other choice.
Since then, Sara has developed facial breakouts, swelling, and new inflammation, with no clear answers.
And Now… It’s Happening Again
In July 2025, Sara’s current home tested positive for multiple strains of toxic mold, and she was diagnosed with severe allergies to dust and dust mites. Sara is currently waiting for her landlord’s response. She’s trying to protect her health and her children’s safety in the meantime.
Though Sara’s daughters aren’t showing symptoms as severely as she is, they still need a detox protocol to help clear the mold exposure from their previous home and prevent long-term effects.
What Sara Misses—and Who She’s Trying to Return To
Before all this, Sara loved volleyball, softball, dancing, traveling, bowling, live music, and spending time with family. She was the PTO president, a school volunteer, and someone who poured energy into the people and causes she believed in.
But the chronic fatigue, joint pain, dizziness, eye issues, and nervous system dysfunction have taken those things from Sara, one by one. She want to live again—not just survive.
Sara is Doing the Work—Body, Mind & Soul
Sara is currently seeing a neurochiropractor weekly after discovering low nerve response in key areas of her spine. These visits are helping to retrain her nervous system and rebuild energy—and she’s hopeful that continued care will help her heal.
She is also committed to whole-person healing and welcomes supportive modalities like: Massage, reiki, acupuncture, sound therapy, yoga, light therapy, sauna sessions, group meditations, qi-gong, and prayer
Any modality rooted in hope, regulation, and restoration
Sara is Choosing to Heal in Hope—Not in Fear
To protect her mental, emotional, and energetic health, Sara kindly asks that this space remain free of fear-driven opinions, speculative diagnoses, or unsolicited medical advice. She’s surrounding herself with compassionate support and grounded solutions, and that is the environment she intends to heal in.
Your Support Will Help With:
Naturopathic visits and advanced testing
Medical appointments, prescriptions, and supplement protocols
Weekly neurochiropractic treatments
Detox protocols and immune support for Sara and her daughters
HEPA vacuums, air purifiers, dust-mite covers, dehumidifiers
Replacement of contaminated furniture, bedding, and essentials
Anti-inflammatory, healing foods and clean water
Emergency relocation, if needed
Continued work creating healing resources for other women navigating chronic illness, ADHD, mold toxicity, and long-COVID symptoms
A Final Note from Sara to All of Her Loved Ones
To all my friends, family, and community:
If at any point I seemed distant or unavailable—please know it was never you. Between working and giving everything I had to my kids, I was often running on empty. I simply didn’t have the energy to show up in the ways I wanted to.
But I’ve always carried you with me. Your love, your presence, your care—it’s meant more than I could express. I’m ready now to rebuild, reconnect, and return to life with the energy and wholeness I’ve missed so deeply.
With all my love and gratitude,
Sara
Organizer and beneficiary
Sara Brand
Beneficiary






